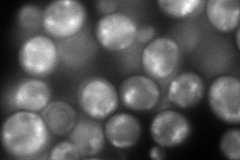
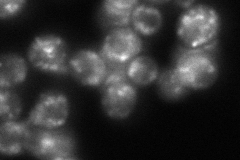

View description
Gamma subunit of coatomer, a heptameric protein complex that together with Arf1p forms the COPI coat; involved in ER to Golgi transport of selective cargo
Localization:
Intensity:
Fold change:
Significance:
-
C’ GFP library in SD

punctate157.43 -
N' NOP1pr-GFP in SD
punctate223.537 -
N' TEF2pr-mCherry in SD

punctate163.392 -
N' NATIVEpr-GFP in SD
punctate112.966 -
N' TEF2pr-VC and Cyto-VN in SD

#N/A0 -
C’ GFP library in SD+DTT

punctate172.131.09No -
C’ GFP library in SD+H2O2

punctate128.440.81No -
C’ GFP library in Starvation Media

punctate149.240.94No -
C’ GFP library on the background of Pup2-DaMP

punctate -
C’ GFP library on the background of CCT mutant

punctate143.8140.913433No
